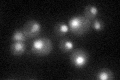
YIL130W
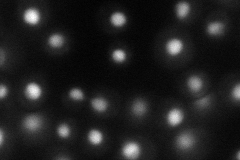
YIL130W
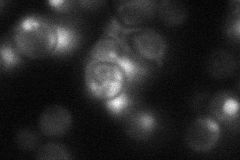
YIL130W
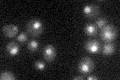
YIL130W

View description
Zinc cluster protein proposed to function as a transcriptional regulator involved in the stress response; null mutants have a respiratory deficiency, calcofluor white sensitivity and slightly increased cycloheximide resistance
Localization:
Intensity:
Fold change:
Significance:
-
C’ GFP library in SD
nucleus32.26 -
N' NOP1pr-GFP in SD
nucleus57.5897 -
N' TEF2pr-mCherry in SD

nucleus48.4916 -
N' NATIVEpr-GFP in SD
nucleus22.7036 -
N' TEF2pr-VC and Cyto-VN in SD

#N/A0 -
C’ GFP library in SD+DTT

nucleus30.040.93No -
C’ GFP library in SD+H2O2

nucleus32.541No -
C’ GFP library in Starvation Media
nucleus28.150.87No -
C’ GFP library on the background of Pup2-DaMP

nucleus -
C’ GFP library on the background of CCT mutant

nucleus31.77860.984534No
